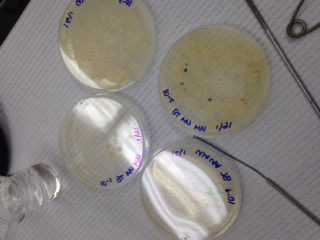
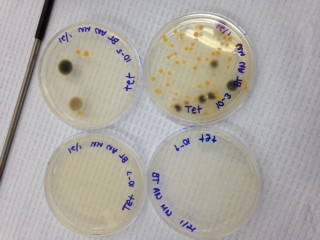

User:Adam Nolan/Notebook/Biology 210 at AU
Start of Notebook
First entry. I'm able to effectively write content in this notebook.
January 14, Lab 1 - Biological Life at AU.
In this lab, the goal was to analyze a specific ecosystem that appears on AU’s campus in a 20 by 20 meter transect of land. The transect we were assigned was the marshland, which was located outside the tunnel, near the road, across the street from the Katzen arts center. We mapped the area, and samples of of vegetation and soil were taken. We attempted to capture as much of the diversity of the area was we could in our sample; including both biotic and abiotic samples. The marshland was rich with vegetation and was very moist. Because it was winter, there was snow littered throughout the area. The west and southwest ends of the marsh were very rocky, while the north and northeast areas were muddy and had lots of taller plants. Large stones were scattered throughout the marsh. Cattails ran along the center of the transect. On the western most corner was a sewer grate where water drained. We recorded what biotic and abiotic factors we found.
Abiotic factors included:
Rocks, metal (sewer grate), soil, light, snow, air, ice.
Biotic factors included:
Grass, moss, cattails, weeds, clovers, cardinal flowers, straw plants, and various shrubs.
After obtaining our sample and mapping the area, we returned to the lab and made a hay-infusion culture with the sample we collected. The hay infusion culture was made by placing 12 grams of our sample into a plastic jar with 500mLs of water. .1gm of dried milk was added, and the solution was gently mixed for 10 seconds. After that it was left uncovered for a week for later observation.
Fig. 1 - A sketch of the marsh transect
January 21, Lab 2 – Identifying Algae and Protists
In this lab, the goal was to analyze the different types of cells present in the hay infusion culture we made in the previous lab from samples we obtained from the marshland transect. We took drops from the top layer of the culture and another from the bottom. Both drops were made into wet mounts and viewed under a microscope in order to identify different types of cells living within. The hay infusion culture smelled rancid, like hot sewage. The water was a yellow color, and a fine layer of silt had collected along the bottom of the jar. A whitish film had developed over the top of the water, and the vegetation from the sample floated near the bottom. The plants were still green, so we could assume they were still alive. The film at the top of the water appeared to be some sort of mold, which we also categorized as alive. The first sample we took was from the very top of the jar, just underneath the moldy film so that water could be drawn out. From the sample, we identified three different types of organisms.
Our hay infusion culture.
Sample 1:
Paramecium Bursaria
-100µm
-Motile
-Green color indicates photosynthesis
-This organism is able to survive in its environment because it’s able to obtain energy (photosynthesis) and move around to get to areas where energy will be most available.
Pandorina
-70µm
-Organized into a colony
-Not motile
-Didn’t appear to use photosynthesis
Blepharisma sp.
-450µm
-Purple color
-Not motile
-No photosynthesis.
Sample 2:
Sample 2 was obtained near the bottom of the jar. Some silt was taken up along with the water.
Ameoba Proteus
-20µm
-Moving/sprouting (motile)
-No photosynthesis
-No color (clear)
Paramecium Bursaria
-50µm
-Motile
-Used photosynthesis (green color)
Colpidium
-60µm
-Motile
-No photosynthesis
-Clear color
January 28, Lab 3 - Microbiology
Week 3, we examined the growth on the agar plates that had developed from the hay infusion over the previous week. Below is a chart labeled "table 1" showing the colonies grown and on which type of plate, followed by photos of our agar plates.
The table shows that there are clearly higher amounts of colony/bacteria growth on the nutrient agar plants without the tet antibiotic, indicating that the antibiotic did work to some capacity, inhibiting bacteria growth.
Fig. 1 - Our nutrient agar plates without the tet antibiotic.
Fig. 2 - Our nutrient agar plates with the tet antibiotic. Gray/black patches are mold and were not sampled..
After identifying the amount of colonies on each plate and their type, we could conclude that there were many more able to grow on the nurtrient agar plates that didn't have the tet antibiotic. This would indicate that the antibiotic had a significant effect on the growth of bacteria on the plates, however, because some of the tet plates did have growth, that shows that there are some resistant strains of bacteria that were still able to grow, albeit in smaller amounts.
In order to observe the bacteria, we had them undergo a gram stain procedure. To get the bacteria samples from the agar plates, a metal loop was sterilized over a flame and used to scrape colonies from the plates. The samples were then mixed into drops of water on four separate slides. The four slides were then passed through the flame three times in order to evaporate the water. The slides were placed on a staining tray and covered with crystal violet dye for one minute, then rinsed off with water. Then, they were then covered with Gram’s iodine mordant for another minute, before washed with water once more. To decolorize the smears, the slides were flooded with 95% alcohol for 20 seconds, and then rinsed with water. The smears were covered with safranin stain for 30 seconds, and then rinsed with water again. Excess water was dried off using kimwipes. After a few minutes of additional air drying, the gram stains were observed with a microscope in low and high magnifications.
Fig 3. The gram-stain slides.
Below is "table 2" characterizing the bacteria visible on our gram stains using the microscope:
We have found that there is a clear difference in colony growth between the two types of plates, indicating that the tet antibiotic had a negative effect on the colony growth of bacteria. Because there was some colony growth in the tet plates though, we can conclude that there are some bacteria living within the hay infusion culture that are resistant to this type of antibiotic. Those colonies that did grow on the tet plates are those antibiotic bacteria.
February 4, Lab 4 - Plants and Fungi
The purpose of this lab was to examine the different types of plant life within our transect, as well as identify them and their various structures such as reproductive methods, vascularization, and otherwise specialized structures.
We did this by going out to the marsh transect with three ziploc bags and gathering as many different types of samples of plants. The plants we obtained were: Moss, hay, cattail, and samples from a "butterfly bush," as well flowering bush. Photos of all of these samples were taken as well. From there, the plants were examined in the lab. We searched each looking for the reproductive method used by the plant, specialized structures, and we cut small sections off to observe under the microscope in order to determine the vascularization of the plant. All findings were recorded in our journals and made into the table below:
In addition to the table, pictures of each plant were taken, as can be seen below:
Figure 1. Flowering Bush.
Figure 2. Cattail Plant.
Figure 3. Hay
Figure 4. Moss
Figure 5. Butterfly Bush.
It's clear that there are many diverse types of plants within just our transect alone. Plants of varying vascularizations, reproductive methods, and special structures. By investigating these organisms, we can gain insight into how each contributes to their environment and ecosystem, and how long they've come via evolution based on the types of complex structures each have developed.
February 11, Lab 5 - Invertebrates and Vertebrates
The purpose of this lab was to further explore the level of diversity of life within the marsh transect. This time, we went beyond plants and bacteria, and looked at different types of vertebrates and invertebrates. First, we broke down our Berlese funnels which we had made the previous week using 500g of leaf litter taken from our marsh transect. This sample came from an area of soft soil covered with dead leaves. In the lab, a Berlese Funnel was then constructed for this leaf litter. First, 25 mL of a 50:50 ethanol/water solution was poured into a 50 mL conical tube. Screening material was then attached to the bottom of the funnel using tape to keep leaves and other large matter from falling into the solution. The leaf litter sample was then placed into the funnel. Next, the funnel was placed in a ring stand, with its lower shoot attached to the conical tube sealed with parafilm. The entire assemly was placed beneath a lit 40 watt lamp, with the light about 1-2 inches from the sample. The lamps and funnels were then covered with foil and left for the week.
To find the invertebrates, we took apart our Berlese funnels and obtained samples from the ethanol/water solution at the bottom that had been collecting falling matter from the litter sample. We took a small sample from the top of the solution, as well as from the bottom. Both samples of the liquid were placed in petri dishes and examined under a microscope for invertebrates. All findings were catalogged, and can be seen in the table below:
All invertebrates were found at the bottom of our solution, and varied from 1250-2500µm in size.
After investigating the invertebrates present in our sample, we researched the different types of vertebrates present within our marsh transect. We identified five different types of vertebrates, and they can be found in the list below:
- The Eastern Grey Squirrel (Sciurus carolinensis) Phylum: Chordata; Class: Mammalia; Order: Rodentia; Family: Sciuridae; Genus: Sciurus; Species: S. carolinensis
- The Field Sparrow (Spizella pusilla) Phylum: Chordata; Class: Aves; Order: Passeriformes; Family: Emberizidae; Genus: Spizella; Species: S. pusilla
- The American Robin (Turdus migratorius) Phylum: Chordata; Class: Aves; Order: Passeriformes; Family: Turdidae; Genus: Turdus; Species: T. migratorius
- The Common Garter Snake (Thamnophis sirtalis) Phylum: Chordata; Class: Reptilia; Order: Squamata; Family: Colubridae; Genus: Thamnophis; Species: T. sirtalis
- The Northern Short-tailed Shrew (Blarina brevicauda) Phylum: Chordata; Class: Mammalia; Order: Soricomorpha; Family: Soricidae; Genus: Blarina; Species: B. brevicauda
With this this data, we were able to construct a food web for our transect.
As we gather more information about the transect, the more we're able to understand how diverse this small plot of land actually is, and how much each organism contributes to forming this ecosystem. We're given a larger perspective about the importance of each living thing in the ecosystem, and how each interacts with the others on different levels.
February 25, Labs 6 & 7 - PCR Sequencing
During the bacteria lab in week 3, we took samples from the bacterial colonies that we grew on the agar plates. We took two samples from the tet agar plates, and from two the plates without the antibiotic. The samples we collected went through a PCR reaction and then placed into to the electrophoresis gel to see which contained the 16s gene sequences. After that, the colonies which exhibited the 16s sequence were sent to get sequenced. Below is a figure of our electrophoresis gel.
Once the sequences were finished PCR, we were able to see the which sample had which bacteria by using the nucleotide BLAST program.
Here are the following sequences for the two genetic samples.
1. Sample 1 Sequence: 97% match with Pseudomonas
(NNNNNNNNNNNNNNNNTGCAGTCGAGCGGANGANGGGAGCTTGCTCCTGGATTCAGCGGCGGACGGGTGAGTNNNGNCTA GGAATCTGCCTGGTAGTGGGGGACAACGTTTCGAAAGGAACGCTAATACCGCATACGTCCTACGGGAGAAAGCAGGGGAC CTTCGGGCCTTGCGCTATCAGATGAGCCTAGGTCGGATTAGCTTGTTGGTGAGGTAATGGCTCACCAAGGCGACGATCCG TAACTGGTCTGAGAGGATGATCAGTCACACTGGAACTGAGACACGGTCCAGACTCCTACGGGAGGCAGCAGTGGGGAATA TTGGACAATGGGCGAAAGCCTGATCCAGCCATGCCGCGTGTGTGAAGAAGGTCTTCGGATTGTAAAGCACTTTAAGTTGG GAGGAAGGGTTGTAGATTAATACTCTGCAATTTTGACGTTACCGACAGAATAAGCACCGGCTAACTCTGTGCCAGCAGCC GCGGTAATACAGAGGGTGCAAGCGTTAATCGGAATTACTGGGCGTAAAGCGCGCGTAGGTGGTTTGTTAAGTTGGATGTG AAAGCCCCGGGCTCAACCTGGGAACTGCATCCAAAACTGGCAAGCTAGAGTACGGTAGAGGGTGGTGGAATTTCCTGTGT AGCGGTGAAATGCGTAGATATAGGAAGGAACACCAGTGGCGAAGGCGACCACCTGGACTGATACTGACACTGAGGTGCGA AAGCGTGGGGAGCAAACAGGATTAGATACCCTGGTAGTCCACGCCGTNNCGATGTCAACTAGCCGTTGGAATCCTTGAGA TTTTAGTGGCGCAGCTAACGCATTAAGTTGACCGCCTGGGGAGTACGGCCGCAAGGTTAAAACTCAAATGAATTGACGGG GGCCCGCACAAGCGGTGGAGCATGTGGTTTAATTCGAAGCAACGCGAANAANCTTANCNNNCTTGACATGCANANAACTT TCCANANATGGATTGGNGCCTTCGGNAACTCTGACNCAGNGCTGCATGNNNGNTCGTCAGCTCGTGTCGTGAGANNNTGN NTNAGTCCCGNTANCNANCGNNNNNCNNGTCCNTANTNNNCAGCNNNTTNTGNNN)
The description for this species is: Gram negative, rod shaped, motile, aerobic, and in favor of watery conditions.
2. Sample 2 Sequence: 98% match with Ralstonia
(NNNNNNNNNNTNNNNNNNNNNNAGTCGNNCGGCANCNNGATCTAGCTTGCTAGATTGATGGCGAGTGGCGAACGGGTGAG TAATACATCGGAACGTGCCCTGTAGTGGGGGATAACTAGTCGAAAGATTAGCTAATACCGCATACGACCTGAGGGTGAAA GTGGGGGACCGCAAGGCCTCATGCTATAGGAGCGGCCGATGTCTGATTAGCTAGTTGGTGGGGTAAAGGCCCACCAAGGC GACGATCAGTAGCTGGTCTGAGAGGACGATCAGCCACACTGGGACTGAGACACGGCCCAGACTCCTACGGGAGGCAGCAG TGGGGAATTTTGGACAATGGGCGAAAGCCTGATCCAGCAATGCCGCGTGTGTGAAGAAGGCCTTCGGGTTGTAAAGCACT TTTGTCCGGAAAGAAATGGCTCTGGTTAATACCTGGGGTCGATGACGGTACCGGAAGAATAAGGACCGGCTAACTACGTG CCAGCAGCCGCGGTAATACGTAGGGTCCAAGCGTTAATCGGAATTACTGGGCGTAAAGCGTGCGCAGGCGGTTGTGCAAG ACCGATGTGAAATCCCCGAGCTTAACTTGGGAATTGCATTGGTGACTGCACGGCTAGAGTGTGTCAGAGGGGGGTAGAAT TCCACGTGTAGCAGTGAAATGCGTAGAGATGTGGAGGAATACCGATGGCGAAGGCAGCCCCCTGGGATAACACTGACGCT CATGCACGAAAGCGTGGGGAGCAAACAGGATTAGATACCCTGGTAGTCCACGCCCTAAACGATGTCAACTAGTTGTTGGG GATTCATTTCCTTAGTAACGTANCTAACGCGTGAAGTTGACCGCCTGGGGAGTACGGTCGCAAGATTAAAACTCAAAGGA ATTGACGGGGACCCGCACAAGCGGTGGATGATGTGGATTAATTCGATGCAACGCGAAAAACCTTACCTACCCTTGACATG CCACTAACGAAGCANANATGCATTANGTGCTCNAAAGAGAAAGTGGANNCNNNGCTGCATGGCTGTCGTCAGCNNCGTGT CGTGANNATGTTNGGGTTAAGTCCCCGCAACGAGCNNCANCCCTTGTCTNCTAGTTGCNNN)
There was not much known about the Ralstonia, but it is known that they belong to the Proteobacteria genus. Proteobacteria can be both non-motile or motile. Additionally, they are gram negative, and anaerobic.
With this information, we are able to understand more about the organisms within our transect on a genetic level.
February 18 - March 4. Zebrafish Lab
Preliminary expectations for the experiment are that the alcohol will have a very negative impact on the growth, development, and survival rates of the zebrafish in the experimental group. The control group is expected to grow at a much more typical rate, and will likely exhibit more signs of traditional health than those zebrafish that are subject to the alcohol treatment. The zebrafish in the experimental group will likely suffer from some sort of stunted growth, or will suffer from abnormal growth patterns. Additionally, they will likely suffer from an increased mortality rate. The overall purpose of the study is to determine the dangers or benefits of a certain condition on the development of these zebrafish embryos, and with those findings, further experiments can be done to test the generalizability of those findings to other types of organisms.
Day 1 (February 18, 2015): Class Lab Day
Hypothesis: Embryos that develop in an experiment where alcohol is present will develop abnormally. I predict that the Zebrafish embryos grown in a solution with a 1.5% alcohol concentration will have body structures and eye sizes that develop abnormally when compared to a controlled environment absent of alcohol. Additionally, I predict that the mortality rates of the Zebrafish embryos in the experimental group will by higher than the mortality rates of the embryos in the control group.
Procedure/Methods 1.
Created a hypothesis and prediction for the lab that will guide our research and experimental plan, then observed Zebrafish embryos. Next, set up control group (20 mL of Deerpark water) and the test group (20 mL of 1.5% Alcohol) in covered petri dishes, both with 20 healthy translucent embryos per dish.
Data & Observations
- Number of Dead Eggs- 0 (both)
- Number of Living Embryos still in Egg Cases- 20 (both)
- Number of Living Hatchlings (Larvae)- 0 (both)
- Number of Dead Hatchlings- 0 (both)
- Eye and Body Structure Observations- N/A (both)
- Other Observations- Small, <1mm in diameter, translucent; development approximately at the 20-somite developmental stage for both groups.
Zebrafish Lab: Observing effects of a 1.5% Alcohol Solution on the Development of Zebrafish.
Day 3 (February 20, 2015): Observation Day
Procedure/Methods 1. Removed 10 mL of water and any empty egg cases from each petri dish 2. Remove any dead (fuzzy looking because mold grows on them) embryos 3. Add 25 mL of water to control dish 4. Add 25 mL of alcohol solution to test petri dish 5. Dead embryos were saved and put into paraformaldehyde 6. Observed Zebrafish
Data & Observations Control:
- Number of Dead Eggs- 0
- Number of Living Embryos still in Egg Cases- 19
- Number of Living Hatchlings (Larvae)- 1
- Number of Dead Hatchlings- 0
- Eye and Body Structure Observations-
- Other Observations- All at or past 48 hour developmental stage; all of the embryos in the control are able to be seen in egg sac
Experimental:
- Number of Dead Eggs- 2
- Number of Living Embryos still in Egg Cases- 18
- Number of Living Hatchlings (Larvae)- 0
- Number of Dead Hatchlings- 0
- Eye and Body Structure Observations-
- Other Observations- Slows development and growth; 6 have embryo visible with naked eye, whereas all of the embryos in the control are able to be seen in egg sac
Day 6 (February 23, 2015): Observation Day
Procedure/Methods 1. Removed 10 mL of water and any empty egg cases from each petri dish 2. Removed any dead (fuzzy looking because mold grows on them) embryos 3. Added 25 mL of water to control dish 4. Add 25 mL of alcohol solution to test petri dish 5. Dead embryos were saved and put into paraformaldehyde 6. Observed Zebrafish
Data & Observations Control:
- Number of Dead Eggs- 2
- Number of Living Embryos still in Egg Cases- 0
- Number of Living Hatchlings (Larvae)- 18
- Number of Dead Hatchlings- 0
- Eye and Body Structure Observations- Uniform, nearly identical, proportional, large
- Other Observations- Lively and active
Experimental:
- Number of Dead Eggs- 11
- Number of Living Embryos still in Egg Cases- 0
- Number of Living Hatchlings (Larvae)- 7
- Number of Dead Hatchlings- 0
- Eye and Body Structure Observations- Small, bloated
- Other Observations- Lethargic
Day 8 (February 25, 2015): Class Lab Day
Procedure/Methods 1. Removed 5 mL of water with any egg cases/dead hatchlings from each petri dish, and added 10 mL fresh water to the control group and 10 mL of test solution to the experimental group 2. Dead embryos/hatchlings were saved and put into paraformaldehyde 3. Add one drop of paramecium to each group of Zebrafish 4. From the control group (not the test group because there are not enough living fish to sacrifice one for preservation and it would be more beneficial to the experiment to continue observing their development), fix one larvae. Add the Zebrafish to a tube using a dropper and add one drop of tricaine solution per mL of water. Later, the TA added paraformaldehyde and stored the sample. Another fixation will occur in a week in the following lab. 5. Observe the Zebrafish.
Data & Observations Control:
- Number of Dead Eggs- 0
- Number of Living Embryos still in Egg Cases- 0
- Number of Living Hatchlings (Larvae)- 18
- Number of Dead Hatchlings- 0
- Eye and Body Structure Observations- Eyes were normal and rotated slightly, both eyes were the same size and moved in conjunction with one another; they moved in rapid short forwards bursts; body structure was normal and uniform among all of the hatchlings
- Other Observations- one control Zebrafish was preserved in the tricaine solution (see Procedure/Methods)
Experimental:
- Number of Dead Eggs- 0
- Number of Living Embryos still in Egg Cases- 0
- Number of Living Hatchlings (Larvae)- 5
- Number of Dead Hatchlings- 2
- Eye and Body Structure Observations- more yellow in color than the muted colored control fish; their movement was more spastic and used more upper body to move than just the tail; the fish varied in size; they generally had shorter and faster moving tails
- Other Observations- One fish (see image) moved very rapidly in place and showed difficulty moving
Day 10 (February 27, 2015): Observation Day
Procedure/Methods 1. Removed 10 mL of water with any egg cases/dead hatchlings from each petri dish, and added 10 mL fresh water to the control group and 10 mL of test solution to the experimental group 2. Dead embryos/hatchlings were saved and put into paraformaldehyde 3. Observe the Zebrafish. Data & Observations Control:
- Number of Dead Eggs- 0
- Number of Living Embryos still in Egg Cases- 0
- Number of Living Hatchlings (Larvae)- 17
- Number of Dead Hatchlings- 0
- Eye and Body Structure Observations- The fish all looked practically identical; eyes moves slightly and rotationally, but also in unison; straight body structure
- Other Observations- movement speed seemed to slow compared to the first few days
Experimental:
- Number of Dead Eggs- 0
- Number of Living Embryos still in Egg Cases- 0
- Number of Living Hatchlings (Larvae)- 4
- Number of Dead Hatchlings-1
- Eye and Body Structure Observations- body is much more yellow in color, and the tail proceeding the fish’s head was curved; the very abnormal fish observed on day 8 had shrank and was found dead in the dish
- Other Observations- the fish moved very rapidly but not at great distances. Also, motion required moving more of its body than control fish, that would only need to move their tails quickly for motility
Day 13 (March 2, 2015): Observation Day
Procedure/Methods 1. Added 10 mL fresh water to the control group and 10 mL of test solution to the experimental group. No water or alcohol solution was removed 2. Dead embryos/hatchlings were saved and put into paraformaldehyde 3. Observe the Zebrafish. a. Measured Heart Rate
Data & Observations Control:
- Number of Dead Eggs- 0
- Number of Living Embryos still in Egg Cases- 0
- Number of Living Hatchlings (Larvae)- 16
- Number of Dead Hatchlings- 1
- Eye and Body Structure Observations- Eyes are black and moving back and forth.
Body length = 145um, tail is long, making up most of the body. The body was yellow-colored and translucent with black speckles. The swim bladder measures about 10um.
- Other Observations- Heart rate measured 48/15 seconds. Swimming & behavior: The fish were lively and active, with fluid tail movements.
Experimental:
- of Dead Eggs- 0
- of Living Embryos still in Egg Cases- 0
- of Living Hatchlings (Larvae)- 2
- of Dead Hatchlings- 3
Eye and Body Structure Observations- Eyes were black and not moving much. Head seemed to be smaller, and eyes closer together. The body measured about 155um, and was translucent with black speckles. The tail was shorter and fatter in comparison to the control. The swim bladder seemed to be absent/undeveloped, and as a result, the fish had problems staying balanced/upright in the water. (Kept rolling onto it’s side.) Other Observations- Heart rate was measured at 45/15 seconds.
Day 15 (March 4, 2015): Class Lab Day
Procedure/Methods 1. Observe the Zebrafish as well as the fixed control Zebrafish from last Wednesday (Day 8) 2. Fix two control larvae. Add the Zebrafish to a tube using a dropper and add one drop of tricaine solution per mL of water. Later, the TA added paraformaldehyde and stored the sample 3. Properly dispose of dead Zebrafish, put the living fish dishes to be preserved, and dispose of the alcohol solution in the waste collection jug
Data & Observations Control:
- Number of Dead Eggs- 0
- Number of Living Embryos still in Egg Cases- 0
- Number of Living Hatchlings (Larvae)- 6
- Number of Dead Hatchlings- 10
- Eye and Body Structure Observations- their eyes were moving, but very minimally; their bodies still had black speckles but were far more yellow in color than before; growth is noticeable in length of the fish. Today they were about 165 ocular spaces at 4x objective and on Monday they were 145 and a week ago (Day 8) were 140 ocular spaces; they still have a swim bladder that is about 10 ocular spaces wide at the x objective lens
- Other Observations- Some protists were found in their water; we used the fixed control Zebrafish to measure eye size of a controlled fish (12 ocular spaces at 4x lens); motility was much slower in pace and smaller range of motion compared to all other days of observation
Experimental:
- Number of Dead Eggs- 0
- Number of Living Embryos still in Egg Cases- 0
- Number of Living Hatchlings (Larvae)- 0
- Number of Dead Hatchlings- 2
- Eye and Body Structure Observations- N/A (Dead)
- Other Observations- N/A (Dead)
Fixed Zebrafish Larvae from February 25 (Day 8)
With these findings, it is safe to say that the original hypothesis can be deemed correct, and that alcohol does indeed have a large array of adverse effects upon the development of the zebrafish. Experiments like these are important for science because they create larger implications that can be applied to other organisms, and show how and in what ways certain substances can be dangerous to any organism’s development. With these findings, it can be concluded that alcohol is very clearly dangerous to the development of not only the zebrafish, but other organisms as well.